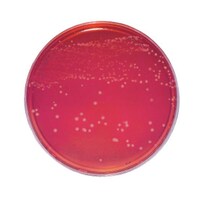

アズワン サーモピット3I@/3IC@(不可逆性・3温表示) 3Iシリーズ
設定温度に達した履歴を残します。食品添加物に認定されている石油系天然ワックスの物性変化を利用しており、鉛・水銀・クロム等環境負荷物質を含まず、安全性が高いです。
設定温度に達した履歴を残します。食品添加物に認定されている石油系天然ワックスの物性変化を利用しており、鉛・水銀・クロム等環境負荷物質を含まず、安全性が高いです。+もっと見る
ヒサゴ A4色上質タックシール
カラータイプは宛名以外にもラッピング・分類用など工夫次第で幅広くご使用いただけます。
カラータイプは宛名以外にもラッピング・分類用など工夫次第で幅広くご使用いただけます。+もっと見る
ブライト標識 サーモデマンド (20枚入) 5R70 研究用 計測器 温度 温度ラベル 1箱(20枚)
指示温度が5点表示で不可逆性単温タイプの温度ラベルです。
指示温度が5点表示で不可逆性単温タイプの温度ラベルです。+もっと見る
貝印カミソリ L20 白刃 大 替刃 #022KZ0191 カッターナイフ 1セット(20枚入)
壁紙、床材を切ることを目的として開発したプロ用大型カッター刃。耐久性重視の白刃。持ち運びしやすい20枚入り。
壁紙、床材を切ることを目的として開発したプロ用大型カッター刃。耐久性重視の白刃。持ち運びしやすい20枚入り。+もっと見る
バイリーン ディスポシーツ 未滅菌 20枚×8袋 W5009 100X90CM シーツ 1箱(20枚入×8)
柔らかタッチのディスポシーツ。吸収素材は水流不織布のため、柔らかい風合いを保持しています。未滅菌。
柔らかタッチのディスポシーツ。吸収素材は水流不織布のため、柔らかい風合いを保持しています。未滅菌。+もっと見る
イワツキ 滅菌APガーゼ No.33 4折タイプ (20枚パック×10袋) 00221503 衛生材料 尺角ガーゼ 1箱(20枚入×10)
滅菌ガーゼ。4辺を裁断、乱糸が出にくい加工済み。必要な折方、枚数が選べます。
滅菌ガーゼ。4辺を裁断、乱糸が出にくい加工済み。必要な折方、枚数が選べます。+もっと見る
日本ベクトン・ディッキンソン フェニルエチルアルコール 5%羊血液寒培地 20枚 212086 培地 その他 1個(20枚)
フェニルエチルアルコール5%ヒツジ血液寒天培地は、StreptococcusやStaphylococcusなどのグラム陽性球菌の選択的分離に用いられます
フェニルエチルアルコール5%ヒツジ血液寒天培地は、StreptococcusやStaphylococcusなどのグラム陽性球菌の選択的分離に用いられます+もっと見る
日本ベクトン・ディッキンソン BD BBL(TM) キャンピロバクター 10%ヒツジ血液寒天培地 20枚 251727 培地 その他 1個(20枚)
本培地は、Campylobacter特にC.jejuniを糞便検体から選択分離するのに適した培地です
本培地は、Campylobacter特にC.jejuniを糞便検体から選択分離するのに適した培地です+もっと見る
日本ベクトン・ディッキンソン BD BBL(TM) スキロー培地 20枚 252111 培地 簡易培地 1個(20枚)
スキロー培地は、Campylobacter特にC.jejiuniを糞便検体から選択分離するのに適した培地です
スキロー培地は、Campylobacter特にC.jejiuniを糞便検体から選択分離するのに適した培地です+もっと見る
極東製薬工業 生培地(バイタルメディア) マンニットソルト卵黄寒天培地 ブドウ球菌の選択分離及び鑑別 20枚入 05661 培地 培地(食品検査用) 1箱(20枚)
高品質の生培地です。
高品質の生培地です。+もっと見る
シナノ製作所 ディスポ飼育ケージ 335×225×135mm 20枚入 SN802D 1箱(20枚)
滅菌済みのディスポーザブルケージのため、ケージの洗浄や滅菌作業を省力化できます。
滅菌済みのディスポーザブルケージのため、ケージの洗浄や滅菌作業を省力化できます。+もっと見る
WATSON 8列リザーバ U底 PP フタ付き 滅菌済 1箱(20枚入) 47608US 実験室用備品 リザーバー 1箱(20枚入)
すべてフタがセットされ個別包装滅菌済みです
すべてフタがセットされ個別包装滅菌済みです+もっと見る
クラレ ソリブ(R) 120×120mm 1ケース(20枚×20袋入) SOLIV1212 マイクロファイバー(超極細繊維)ワイパー その他 1ケース(20枚入×20)
超極細繊維の扁平かつシャープな断面による優れた拭き取り効果を発揮します。
超極細繊維の扁平かつシャープな断面による優れた拭き取り効果を発揮します。+もっと見る
アズワン ウレタネックスロング手袋 20枚入 8304201 1箱(20枚入)
柔軟性と弾力性に優れ、肌触りがソフトです。高い透湿性・耐油性・耐薬品性を持っています。袖口にずれ落ち防止のゴム付きです。
柔軟性と弾力性に優れ、肌触りがソフトです。高い透湿性・耐油性・耐薬品性を持っています。袖口にずれ落ち防止のゴム付きです。+もっと見る
ニチバン カテリープラスパッド 1箱(20枚入) CPSP0915 衛生材料 パッド付きドレッシング 1箱(20枚)
高透湿性フィルムドレッシング材を使用し、肌にさらさら、低刺激。ガーゼ10枚分以上の高吸収性パッド使用。
高透湿性フィルムドレッシング材を使用し、肌にさらさら、低刺激。ガーゼ10枚分以上の高吸収性パッド使用。+もっと見る
ハクゾウメディカル エレファ器械台カバー(仮固定用テープ付) HZKC1518 150cm×180cm 20枚 3183005 医療材料 機械台カバー 1箱(20枚)
手術・処置などに使用する吸水・防水タイプの滅菌ドレープです。
手術・処置などに使用する吸水・防水タイプの滅菌ドレープです。+もっと見る
トーヨー 色画用紙
+もっと見る
アズワン 吸水防水シーツ(ポリマーシート) 600×900 1袋(20枚入) 80g 8827901 診察台カバー 1袋(20枚入)
吸収力に優れたディスポタイプのシーツです。手術等、水分を伴う処理時の汚染防止に使用できます。
吸収力に優れたディスポタイプのシーツです。手術等、水分を伴う処理時の汚染防止に使用できます。+もっと見る
ヘッズ ギフトバッグ クリスマス プチキュート
ぬいぐるみや大きなおもちゃもすっきり入るクリスマス用のビッグサイズのギフトバックです。特大サイズなので、包装が難しい大きいもののラッピングもカンタンにできます。
ぬいぐるみや大きなおもちゃもすっきり入るクリスマス用のビッグサイズのギフトバックです。特大サイズなので、包装が難しい大きいもののラッピングもカンタンにできます。+もっと見る
Conni(コニー) 吸水・防水シーツ/寝具プロテクター L 20枚入 業務用 CEG100100252 シーツ・寝具・枕 マットレス 1セット(20枚)
尿漏れやおねしょ、寝汗対策におすすめな吸水性・保水性・通気性に優れたベッドパッドです。
尿漏れやおねしょ、寝汗対策におすすめな吸水性・保水性・通気性に優れたベッドパッドです。+もっと見る
Conni(コニー) 吸水・防水シーツ/寝具プロテクター M 20枚入 業務用 CEG085095252 シーツ・寝具・枕 マットレス 1セット(20枚)
尿漏れやおねしょ、寝汗対策におすすめな吸水性・保水性・通気性に優れたベッドパッドです。
尿漏れやおねしょ、寝汗対策におすすめな吸水性・保水性・通気性に優れたベッドパッドです。+もっと見る
ビットストロング NIOSH認証 N95マスク(カップ型)20枚入 ZYB11 感染予防・個人防護具 N95マスク 1箱(20枚)
米国NIOSH(労働安全衛生研究所)認定のN95マスクです
米国NIOSH(労働安全衛生研究所)認定のN95マスクです+もっと見る
アズワン 使い捨て式防じんマスク (DS2) 排気弁無 1箱(20枚入) 3814201 カップ型防じんマスク(DS2,N95等) 1箱(20枚)
ノーズパッドで調節ができる為、密閉性が高いです。
ノーズパッドで調節ができる為、密閉性が高いです。+もっと見る
岩田紙器 メディクリーナ 21LW 20枚入り 63559990 感染予防・個人防護具 廃棄ボックス 1ケース(20枚)
特殊カートン紙・厚板紙・外箱の構造です。
特殊カートン紙・厚板紙・外箱の構造です。+もっと見る
岩田紙器 メディクリーナ 40L(s) 20枚入り 63559993 廃棄ボックス その他感染予防品 1ケース(20枚)
箱底ワンタッチ式なので組立が簡単です。
箱底ワンタッチ式なので組立が簡単です。+もっと見る
岩田紙器 メディクリーナ 50L 20枚入り 63559996 感染予防・個人防護具 廃棄ボックス 1ケース(20枚)
箱底ワンタッチ式なので組立が簡単です。
箱底ワンタッチ式なので組立が簡単です。+もっと見る
三洋 遺体収納袋 1箱(20枚入) 64973685 医療材料 尊体処置 1箱(20枚)
ご遺体の確認時においてファスナーを開けることなく、透明窓のカバーをめくることにより身元確認ができます。
ご遺体の確認時においてファスナーを開けることなく、透明窓のカバーをめくることにより身元確認ができます。+もっと見る
コットン・ラボ コットン・ラボ セフティハンター厚手大判20枚 1セット(8個入)
「コットン・ラボ セフティハンター厚手大判20枚」●200×250mmの大判サイズで、テーブルなど広範囲の場所に最適なしっかりとした厚手タイプの除菌用ウエットティシュ。●無香料。
「コットン・ラボ セフティハンター厚手大判20枚」●200×250mmの大判サイズで、テーブルなど広範囲の場所に最適なしっかりとした厚手タイプの除菌用ウエットティシュ。●無香料。+もっと見る
ネクスタ ひも付きイージーポリ袋3L用20枚 1セット(22個入)
ひも付き3L用ポリ袋20枚。結びやすくて容量いっぱいに使用できる。デスク周りの小さなゴミ箱や小物入れに使える。おしゃれな印刷付き。
ひも付き3L用ポリ袋20枚。結びやすくて容量いっぱいに使用できる。デスク周りの小さなゴミ箱や小物入れに使える。おしゃれな印刷付き。+もっと見る
エスコ カッティング砥石(20枚)23.8x1.0mm
+もっと見る
エスコ チューブパッチ(20枚)150x70mm
+もっと見る
エスコ マスク(20枚)[N95/ML]
+もっと見る
エレコム 兼用ラベル 下地がすけないタイプ
書類や封筒などの訂正におすすめの兼用ラベル。下地を隠す特殊加工をプラスしました。
書類や封筒などの訂正におすすめの兼用ラベル。下地を隠す特殊加工をプラスしました。+もっと見る
エーワン ラベルシール プリンタ兼用 マット紙 ファイル背面用 A4
各種プリンタで印刷できる、厚口の上質紙を使ったインデックスラベルシールです。書類の分類、見出しの作成に。
各種プリンタで印刷できる、厚口の上質紙を使ったインデックスラベルシールです。書類の分類、見出しの作成に。+もっと見る
エスコ 平ワッシャー(どぶメッキ/20枚)
+もっと見る
エスコ 平ワッシャー(ナイロン製/20枚) M14
+もっと見る
エスコ マスク(防塵用/20枚)[DS2]
+もっと見る
山崎産業 カート・ダストボックス用ポリ袋
リサイクルカート、ダストカートや大型ダストボックスにつけられるポリ袋。容量約150L。1袋=20枚入り。
リサイクルカート、ダストカートや大型ダストボックスにつけられるポリ袋。容量約150L。1袋=20枚入り。+もっと見る
オカモト化成品 業務用レッドキーパー
+もっと見る
エーワン ラベルシール レーザープリンタ専用 耐水紙 水に強い A4
レーザープリンタで印刷できる、水に強い耐水紙素材のラベルシールです。ラベル表面と側面に耐水性がありトナーがにじみにくい。パッケージラベル、ギフト、ラッピングシール作成に。
レーザープリンタで印刷できる、水に強い耐水紙素材のラベルシールです。ラベル表面と側面に耐水性がありトナーがにじみにくい。パッケージラベル、ギフト、ラッピングシール作成に。+もっと見る
アズワン 樹脂サンプルプレート 硬質PVC・グレー
+もっと見る
アズワン 樹脂サンプルプレート 硬質PVC・クリア
+もっと見る

![エスコ マスク(20枚)[N95/ML]](/images/goods/main/large/3595938a.jpg)







![エスコ マスク(防塵用/20枚)[DS2]](/images/goods/main/large/3595973a.jpg)







